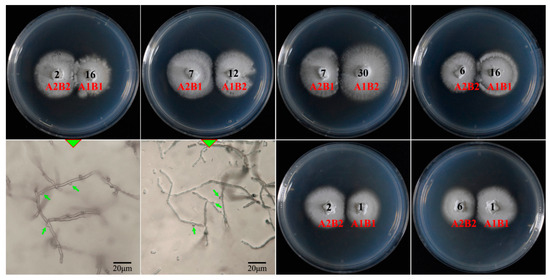

Abstract
Polyporus umbellatus is a species whose sclerotia have been extensively employed in traditional Chinese medicine, which has diuretic, antitumor, anticancer, and immune system enhancement properties. However, prolonged asexual reproduction has resulted in significant homogenization and degeneration of seed sclerotia. In contrast, sexual reproduction has emerged as an effective strategy to address these challenges, with a distinct mating system serving as the foundation for the implementation of sexual breeding. This study presents the first sequencing and assembly of the genome of P. umbellatus, thereby providing an opportunity to investigate the mating system at the genomic level. Based on the annotated mating-type loci within the genome, monokaryotic offspring exhibiting different mating-types were identified. Through the integration of traditional mating tests, the tetrapolar mating system of P. umbellatus was distinctly elucidated. The resequencing of monokaryotic strains with four different mating-types, along with comparative analyses of mating-type loci, revealed the HD1 and HD2 (HD, homeodomain) genes determined the mating A types, and the PR4, PR5, and PR6 (PR, pheromone receptor) genes determined the mating B types. Meanwhile, this study offers a successful case study in the molecular investigation of mating systems. Additionally, the number of sterigma and basidiospores on each basidium was examined using scanning electron microscopy, while the nuclei of basidiospores and basidia at various developmental stages were analyzed through DAPI staining. This research clarifies the heterothallic life cycle of P. umbellatus. The findings of this study are expected to facilitate advancements in genetic research, breeding development, strain improvement, and the industry of P. umbellatus.
1. Introduction
Polyporus umbellatus (Pers.) Fr. is a member of the Polyporaceae family within the Basidiomycota phylum (https://www.indexfungorum.org/, accessed on 8 November 2024). This wood-decay fungus is widely distributed across the temperate regions of the Northern Hemisphere [1]. In China, the sclerotia of P. umbellatus are referred to as “Zhuling” and have been utilized in traditional medicine for over 2500 years [2]. They are also documented in various editions of the Chinese Pharmacopoeia [3]. The fruiting body of P. umbellatus consists of numerous caps that arise from a common stem [4,5]. In China, this mushroom is known as “Zhuling Mo”, which translates to “Zhuling mushroom”, and is recognized as a rare edible species. Recent advancements in pharmaceutical research have highlighted various bioactive properties of P. umbellatus sclerotia. In addition to its traditional diuretic effects [3], it has been reported to possess protective effects against renal fibrosis [6], anticancer properties [7], and antiviral activity [8].
The discovery of various medicinal properties has led to an increased demand for the sclerotia of P. umbellatus. Consequently, the excessive harvesting of this limited natural resource poses a threat to the survival of P. umbellatus [9]. Currently, this species has been included in the China Red Book since 2008 [10] and is also listed in the Red Data Book of Ukraine [11]. Additionally, it is recognized as endangered in Croatia, the Czech Republic, Hungary, Latvia, and Norway, while it is classified as threatened in Denmark, Finland, Great Britain, Sweden, and The Netherlands [12]. Fortunately, artificial cultivation of P. umbellatus was successfully initiated in China over 40 years ago [13], providing a new source of medicinal materials. Currently, the sclerotia of P. umbellatus are widely cultivated in the provinces of Shaanxi, Shanxi, Henan, Sichuan, and Yunnan in China [14]. It is estimated that the annual yield of P. umbellatus sclerotia in China is approximately 3000 tons.
Sexual reproduction enables organisms to generate novel combinations of alleles, thereby enhancing the potential fitness of their offspring [15]. However, the sclerotia of P. umbellatus can only be cultivated by utilizing the sclerotia as to produce new sclerotia through asexual reproduction. Prolonged asexual cultivation of sclerotia has resulted in significant homogenization and degeneration of the seed sclerotia. Unfortunately, the fruiting bodies of P. umbellatus are formed only sporadically, despite their potential to produce sexual offspring. The conditions for the artificial induction of fruiting bodies in P. umbellatus remain unclear. To date, only Pasailiuk (2020) has reported the artificial cultivation of P. umbellatus fruiting bodies, although no mature or normal fruiting bodies were observed [12]. Recently, successful crossbreeding has been achieved through the use of conidia of P. umbellatus, providing a new avenue for sexual breeding [16].
The distinct mating system serves as a fundamental basis for conducting genetic research and sexual breeding to a significant extent. Krueger (2002) was the first to report the tetrapolar mating system of P. umbellatus and several other species within the genus Polyporus in his doctoral dissertation. This report was unique, but which included only a self-crossing chart, it lacked comprehensive information, including details regarding the morphology of the colony [17]. Consequently, more thorough investigations are necessary. Furthermore, advancements in genetics have revealed that mating is regulated by mating-type loci [18]. Two mating-type loci A and B control the mating in tetrapolar species, and only mating-type locus A control mating in bipolar species. The mating-type locus A containing a divergently transcribed pair of HD (homeodomain) 1 and HD2 genes, which regulates nuclear pairing, clamp cell formation. and coordinated nuclear division [18,19]. The mating-type locus B contains PR (pheromone precursor) and PP (pheromone receptor) genes [20,21], promoting septal dissolution, nuclear migration towards the apical cell, and clamp cell fusion [18,19]. The increasing availability of genomic information has facilitated the study of mating-type loci, which remain largely unknown for P. umbellatus.
The objective of this study was to elucidate the mating system and life cycle of P. umbellatus at the molecular level. In this study, the genome of P. umbellatus was sequenced and assembled for the first time, and mating-type loci were identified. By integrating data from the mating-type loci with traditional mating tests, the tetrapolar mating system of P. umbellatus was elucidated, contributing to a successful case study in the molecular investigation of mating systems. Additionally, the distinct heterothallic life cycle of P. umbellatus was characterized. This study provides genetic and molecular evidence regarding the mating system and life cycle of P. umbellatus, which may facilitate advancements in genetic research, breeding development, strain improvement, and the industry surrounding P. umbellatus.
2. Materials and Methods
2.1. Fruiting Body Collection and Monokaryotic Offspring Isolation
The fruiting bodies of fungi are fundamental for the investigation of their mating systems. However, the artificial induction of the fruiting body of P. umbellatus has not yet been successfully achieved. Therefore, it is essential to collect fruiting bodies from natural habitats to explore the mating system. In this study, fruiting bodies were collected from Changbai Mountain in Jilin Province, which has been designated as Pu-F2 in our previous study [16]. The methodologies for spore print collection, preparation of spore suspension, spreading and collection of single spore isolates (SSIs), as well as the identification of monokaryotic offspring, adhere to the protocols of our earlier study [16]. In this study, one of the verified monokaryotic offspring (SS1) was used to conduct genome sequencing (accession number: JBGTYJ000000000), and totally 19 monokaryotic strains were used to distinguish mating-types.
2.2. DNA Preparation, Genome Sequencing, and Assembly
In contrast to traditional methods that utilize liquid fermentation for sample preparation, the mycelia of P. umbellatus exhibited slow growth in liquid media. While the spawn cultured on PDA plates, some clumps of mycelia formed (Figure 1C). These clumps were collected to extract DNA for genome sequencing.

Figure 1.
Basidiospores, germination, and monokaryotic strains of Pu-F2. (A) Basidiospores of Pu-F2. (B) Spore germination after cultured 33 d on PDA media under 25 °C. (C) Monokaryotic strain SS1 of Pu-F2 cultured 45 d on PDA media under 25 °C. (D) Monokaryotic mycelia of strain SS1.
The total genomic DNA was extracted using the conventional CTAB method, and its quality was assessed using the Nanopore One spectrophotometer (NanoDrop Technology, Wilmington, DE, USA) and the Qubit 3.0 Fluorometer (Life Technologies, Carlsbad, CA, USA). The library preparation followed standard protocols for the respective kits. The Illumina NovaSeq 6000 platform and PromethION platforms (Oxford Nanopore Technologies, Oxford, UK) were used for genome sequencing at Wuhan Benagen Tech Solutions Company Limited (Benagen, Wuhan, China).
Raw sequencing data underwent quality assessment and were processed using Oxford Nanopore GUPPY (version 0.3.0) to eliminate unsuccessful reads. The remaining passed reads were used for further analysis. For genome assembly, the software NECAT (https://github.com/xiaochunle/NECAT, accessed on 29 November 2023) was used for preliminary genome assembly, and Racon (version 1.4.11) was utilized for error correction based on ONT sequencing data for two rounds. Further, the software Pilon (version 1.23) was used for error correction based on Illumina sequencing data for two rounds [22]. The Circos graph of the genome was generated using the ‘Advanced Circos’ module of TBtools version 2.086 [23]. The integrity of the genome assembly was estimated using BUSCO (version 4,1,2) [24].
2.3. Repeat Annotation, Gene Prediction, and Function Annotation
The combination of ab initio prediction, homology-based prediction, and transcriptome-assisted prediction was used to identify the genes encoding proteins. Combining different prediction strategy can provided a more precise results of coding genes. The software Exonerate (version 2.4.0) was used for homology-based prediction. Augustus (version 3.3.2), Genescan (version 1.0), and GlimmerHMM (version 3.0.4) were employed for ab initio prediction. StringTie (version 2.1.4) and TransDecoder (version 5.1.0) were utilized for transcriptome-assisted prediction. Finally, the software MAKER (version 2.31.10) was used to integrate gene prediction results.
For gene functional annotation, nine databases were utilized, including the UniProt (https://www.uniprot.org (accessed on 29 November 2023)), Pfam (http://pfam.xfam.org/ (accessed on 29 November 2023)), RefSeq (https://www.ncbi.nlm.nih.gov/refseq/ (accessed on 29 November 2023)), Non-Redundant Database (NR, https://ftp.ncbi.nlm.nih.gov (accessed on 29 November 2023)), InterProScan (https://github.com/ebi-pf-team/interproscan (accessed on 29 November 2023)), Clusters of Orthologous Genes (COG, https://www.ncbi.nlm.nih.gov/COG/ (accessed on 29 November 2023)), Kyoto Encyclopedia of Genes and Genomes (KEGG, http://www.genome.jp/kegg/ (accessed on 29 November 2023)), and Pathway and Gene Ontology (GO, http://geneontology.org (accessed on 29 November 2023)) databases. That ensures a comprehensive prediction of gene functions and involved biological processes.
2.4. Genome Resequencing
The sample preparation methods are the same as those in Section 2.2. A total of 4 strains, with different mating-types, were subjected to genome resequencing. The genome was sequenced using the high-throughput sequencing instrument DNBSEQ-T7 (BGI, Shenzhen, China). This Whole Genome Shotgun project has been deposited at GenBank under the accession numbers: SRR31745029, SRR31745030, SRR31745027, SRR31745028, and the assembled genomes have been deposited under the accession numbers: JBJZPE000000000, JBJZPF000000000, JBJZPG000000000, JBJZPH000000000.
2.5. Mating-Type Identification Based on Mating-Type Genes
According to the annotated mating-type A and mating-type B loci, four pairs of primers were designed. Two of these primers were developed based on the HD1 gene of the mating-type A locus, while two were designed based on the PR4 and PR5 genes of the mating-type B locus. The sequences of the primers are as follows:
HD1p1F1: 5′-GTGACTAGATCGAACAAAGCTTGC-3′;
HD1p1R1: 5′-GTCCAGTTGTCCCGACCTGAATC-3′;
HD1p2F2: 5′-GATGGATGATTCTCGACAGTATTCC-3′;
HD1p2R2: 5′-CTGAGACCTCAATGCATCTGTTC-3′;
PR4F1: 5′-GCCATTGTTGTCTTGATTCCTCTTC-3′;
PR4R1: 5′-CGATGCGAGAATAACGTTGAACTG-3′;
PR5F1: 5′-CAATCTTTGCTTTCCTTGGTCTC-3′;
PR5R1: 5′-CGAGATAGGGACAAGTATAAGCAG-3′.
The genomic DNA of different monokaryotic offspring were extracted from mycelia using a modified CTAB method [25]. The PCR was conducted in a total volume of 25 µL, which included 2 µL of DNA template, 1 µL each of forward and reverse primers, 12.5 µL of 2× mix (Vazyme, Nanjing, China), and 10.5 µL of ddH2O. The PCR was conducted with T100TM Thermal Cycler (BIO-RAD, Hercules, CA, USA), and conditions were as follows: an initial denaturation at 95 °C for 5 min, followed by 35 cycles consisting of denaturation at 95 °C for 30 s, annealing at 55 °C for 30 s, and extension at 72 °C for 30 s. The reaction was concluded with a final extension at 72 °C for 10 min and subsequently stored at 4 °C. The amplified products were subjected to separation via electrophoresis on a 1.0% agarose gel. The results of the electrophoresis indicated that the monokaryotic offspring were categorized into distinct mating-types.
2.6. Mating Experiments
Mon-to-mon pairing tests were performed among homokaryotic offspring to evaluate mating compatibility. Spawn blocks were inoculated onto PDA plates with a diameter of 60 mm, ensuring a spacing of 1 cm between each block. All plates were incubated at a temperature of 25 °C until the colonies of the various strains made contact with one another. Following this initial contact, the cultures were maintained for several additional days. The formation of clamp connections in the contact zones was examined using a light microscope.
2.7. Observation of Hymenium by Scanning Electron Microscope (SEM)
The fruiting bodies of Pu-F2 were fixed using 2.5% glutaraldehyde (McLean Biochemical Technology, Shanghai, China) in a 0.1 M buffer at a temperature of 4 °C for a duration of 24 h. Following fixation, the glutaraldehyde was removed through three washes with deionized water. The samples were then subjected to a dehydration process using increasing concentrations of ethanol: 70%, 85%, 95%, and 100%. Subsequently, the samples were affixed to stubs, coated with a thin conductive layer, and examined using a scanning electron microscope (JEOL, JSM-6510LV, Tokyo, Japan) after undergoing freeze-drying and gold sputtering (JEOL, JFC-1600, Japan).
2.8. Nuclear Fluorescent Staining of Hymenium and Basidiospores
The hymenium and basidiospores were collected using sterilized pipette tips from the fruiting body and spore print, and subsequently mixed with 5 μL of a 10 μg/mL solution of 4′,6-diamidino-2-phenylindole (DAPI, Gen-View, El Monte, CA, USA) for a duration of 2 min in a dark environment. The sample was then examined under a fluorescence microscope (Axioimager A2; Zeiss, Göttingen, Germany) utilizing an excitation wavelength of 340 nm and an emission wavelength of 488 nm. The number of nuclei present in basidia and basidiospores were recorded.
3. Results
3.1. Basidiospore Isolation and Monokaryotic Offspring Identification
The basidiospores of P. umbellatus are cylindical (ratio of length/width, Q > 2.0, Figure 1A), which were germinated to visible colony after 12 d. The germination ratio of basidiospores were 30.2%, 25.7%, and 29.1% for three replicates (Figure 1B). Colonies of monokaryotics strains (Figure 1C) were similar to those of the dikaryotic strain [16], while the mycelia of monokaryotic strains had no clamp connections (Figure 1D). More than 30 monokaryotic offspring of Pu-F2 were collected in this study.
3.2. Genome Sequencing, Assembly, and Annotation of P. umbellatus
A de novo genome assembly was performed by integrating Nanopore long-read sequencing and Illumina short-read sequencing (Figure 2). A genome of 71.68 Mb was assembled based on 7,119,902 Nanopore reads (~150× coverage, 10.59 GB data size), which consists of 27 contigs with a contig N50 ~5.02 MB, with the longest contig being 6.57 MB (Table 1). A large amount of original sequencing data ensures the integrity of genomic data, and the length of the contig N50 indicates a high assembly quality. The genome size of P. umbellatus is relatively large in the Polyporales, being smaller only than Postia placenta (90.93 Mb), Porosteum spadiceum (85.20 Mb), Perenniporia subacida (81.17 Mb), and Ganoderma boninense (79.19 Mb). It is also larger than the sclerotia-formation fungus Wolfiporia hoelen (Chinese Fuling, 64.44 Mb, [26]) (Supplementary Table S1). The mapping rate of Illumina data is 99.86%, the genome coverage is 99.97%, and 97.2% of complete BUSCOs all indicate the good genome integrity of P. umbellatus (Supplementary Tables S2 and S3).

Figure 2.
Circos graph of genome characteristics of Polyporus umbellatus. (A) 14 contigs; (B) repeat sequences of which transposons are in green and tandem repeat in pink; (C) non-coding RNA (ncRNA); (D) gene density; (E) large fragment duplication.

Table 1.
P. umbellatus genome assembly and functional annotation.
A large number of repetitive sequences were annotated in P. umbellatus strain PuF2-SS1, accounting for 61.95% of the whole genome. Among these, 44.66% are transposons, 1.78% are tandem repeats, and 15.51% are unknown repetitive sequences. For transposons, 7.72% are Class II (transposon) and 36.94% are Class I (retrotransposon). Retrotransposons consisted of 32.62% long terminal repeats (LTRs), 4.21% long interspersed nuclear elements (LINEs), and 0.06% short interspersed nuclear elements (SINEs). The most abundant LTRs were Gypsy, accounting for 25.16% of the genome. Transposons only account for 7.72% of DNA transposons. Approximately 1.78% of the genome was identified as tandem repeats, with a total of 1231 SSRs identified (Table 2). The ratio of repetitive sequences of P. umbellatus was more than that of W. hoelen (48.56%) which have high ratio repetitive sequences among different species [26].

Table 2.
Classification of the repeat sequences in the genome of P. umbellatus.
A total of 9574 genes were predicted based on de novo prediction, homology prediction, and RNA–seq prediction, with an average sequence length of 2715.65 bp. Each predicted gene contained 6.87 exons with an average length of 313.36 bp and 5.87 introns with an average length of 96.14 bp (Supplementary Table S4). 97.3% complete BUSCOs of gene prediction indicate the high annotation quality of P. umbellatus (Supplementary Table S5). To obtain comprehensive gene function information, all 9574 genes were annotated in various databases. Most of these genes were mapped using the Nr database, followed by Uniprot, InterProScan, RefSeq, GO, Pfam, KEGG, Pathway, KOG, and TigerFam (Table 1). For the non-coding genes, 766 ncRNAs were predicted, including 66 rRNAs, 21 snRNAs, 678 tRNAs, and 1 miRNA, which collectively occupied 0.198% of the genome (Supplementary Table S6).
3.3. Mating Loci of P. umbellatus
The initial genome analysis of the monokaryotic strain Pu-F2-SS1 of P. umbellatus revealed the mating-type A (MAT-A) and B (MAT-B) loci, which were located on Contig 2 and Contig 10, respectively (Figure 3A). In basidiomycetes, the mating-type A and B loci are typically situated on different chromosomes in species exhibiting a tetrapolar mating system, indicating that these loci are unlinked. This observation is consistent with the findings for P. umbellatus, as examined in this study.

Figure 3.
Mating-type loci of P. umbellatus. (A) MAT-A and MAT-B loci. (B) Protein three-dimension structure of HD1 and HD2 proteins predicted using SWISS-MODEL. (C) Trans-membrane-spanning domain of six PR proteins predicted using TMHHM.
3.3.1. Mating-Type Locus A
The mating-type locus A contains a pair of HD (homeodomain) genes that exhibit different coding orientations. Additionally, the β-fg (β-flanking) and MIP genes are located upstream and downstream of the HD1-HD2 pair, respectively, as annotated in this study. The MIP gene is situated in close proximity to HD2 and exhibits a “head-to-head” coding direction. In contrast, the β-fg gene is positioned upstream of HD1, approximately 110 kb away, and has a reverse coding direction (Figure 3A). Notably, there are numerous repetitive sequences between the β-fg region and HD1, which is consistent with findings in W. hoelen [26]. The HD1 gene is 1374 bp in length, while HD2 is 1413 bp long; the corresponding proteins for HD1 and HD2 consist of 457 and 470 aa, and which contain three and four introns separately (Supplementary Figure S1). The three-dimensional structures of the HD1 and HD2 proteins were constructed using SWISS-MODEL, revealing that both proteins possess the conserved structural features characteristic of homeodomain (Figure 3B). In the phylogenetic tree, the HD1 and HD2 cluster on different branches with high bootstrap value, which shows the genes HD1 and HD2 were formed prior to the species formation of P. umbellatus. Meanwhile, the HD genes exhibit similarities to species within the Polyporales, suggesting that the evolution of HD genes is closely correlated with phylogenetic relationships (Figure 4A).

Figure 4.
Phylogenetic analysis based on protein sequences of mating-type genes using PlyloSuite. (A). IQ-TREE of HD genes. (B). IQ-TREE of PR genes.
3.3.2. Mating-Type Locus B
In the genome of P. umbellatus, six PR (pheromone receptor) genes (PR1-PR6) (Pu7325, Pu7328, Pu7329, Pu7330, Pu7333, Pu7336) have been annotated (Figure 3A). The MAT-B loci span 48 kb from PR1 to PR6. The lengths of the PR genes range from 1505 bp to 1846 bp, with corresponding protein lengths varying from 407 aa to 579 aa (Supplementary Table S7). No pheromone precursors were identified through open reading frame (ORF) prediction and conserved motif searches in the upstream and downstream regions of the PR genes. Among the six PR genes, PR2 is located in proximity to PR3, PR4 is located in proximity to PR5 and PR6, while PR1 is situated separately. Different PR genes have distinct gene structure, the exons varies from three to six (Supplementary Figure S2). All six PR genes possess seven possible transmembrane-spanning domains, and three of which high accuracy as predicted by TMHMM (https://services.healthtech.dtu.dk/services/TMHMM-2.0/, accessed on 5 September 2024) (Figure 3C), which serves as an identifying characteristic. Obviously, the proteins are not highly conserved, only 11 amino acids are consistently conserved among the six PR genes of P. umbellatus (Supplementary Figure S3). In the phylogenetic tree, the six PR genes cluster into distinct branches with high bootstrap values, indicating that these different PR genes were formed prior to the species formation of P. umbellatus. Furthermore, all PR genes exhibit similarities to species within the Polyporales, suggesting that the evolution of PR genes is closely correlated with phylogenetic relationships (Figure 4B).
3.4. Mating-Type Discrimination Based on Mating-Type Loci
The PCR products of genomic DNA of different monokaryotic offspring were analyzed using electrophoresis on an agarose gel (Figure 5). The clear amplified bands of ITS represents the high-quality of DNA templates, and high similarity of electropherograms obtained between the two primers designed for HD1, as well as between those for PR4 and PR5, demonstrate the reliability of the results. Based on the electrophoresis findings, the monokaryotic strains were classified into four distinct types (Figure 5), which present the tetrapolar mating system of P. umbellatus. Given that the HD genes are located on the mating A loci and the PR genes are situated on the mating B loci, the similar electropherograms of HD indicate the same mating-type A, while the analogous electropherograms of PR indicate the same mating-type B. Strains SS9 and SS16 exhibited similarities to strain SS1, which was the genome-sequenced strain in this study, and were designated as mating-type A1B1. The mating-type of strains SS2, SS6, SS8, SS17, and SS36 were classified as A2B2, while strain SS7 was designated as A2B1. Additionally, the mating-types of strains SS38, SS26, SS23, SS35, SS5, SS30, SS12, SS27, SS29, and SS45 were classified as A1B2.

Figure 5.
Identification of mating-types based on the analysis of mating-type loci. Strains that successfully amplified the genes HD1 and PR were designated as A1B1. In contrast, only the gene HD1 was successfully amplified and designated as A1B2, while only the gene PR was successfully amplified and designated as A2B1. Notably, both genes HD1 and PR failed to amplify the designation A2B2. The “SS” was omitted in the figure.
3.5. Mating Verification of Mating-Types
Based on the results obtained from the analysis of mating-type loci, a total of seven strains were selected for mating tests. These included strains SS1 and SS16, which possess mating-type A1B1; strains SS2 and SS6, which exhibit mating-type A2B2; strains SS12 and SS30, which carry mating-type A1B2; and strain SS7, which has mating-type A2B1. The outcomes of the mating tests were consistent with the previously identified mating-types. In the mono-to-mono pairing tests involving the selected seven strains, strains SS1 and SS16 were able to mate with strains SS2 and SS6, while strain SS7 successfully mated with strains SS12 and SS30 (Figure 6). The formation of clamp connections served as an indicator of successful mating (Figure 6). Conversely, visible reactions between colonies provided limited evidence of mating. For instance, the contact reaction observed between strains SS2 and SS1 was similar to that between strains SS2 and SS30, despite the fact that these pairings resulted in successful and unsuccessful mating, respectively (Supplementary Figure S4). Additionally, the contact reaction between strains SS2 and SS16 bore similarities to that between strains SS12 and SS16 (Supplementary Figure S4).
Figure 6.
The mating verification of the monokaryotic strains exhibiting different mating-types. The Petri plates demonstrated successful mating across all six pairs of combinations. Microscopic analysis revealed the successful mating (clamp connection formation) between strains SS2 and SS16, as well as between strains SS7 and SS12. The “SS” was omitted in the figure.
3.6. Discrepancy Between Mating-Type Loci A1 and A2, and B1 and B2
Four monokaryotic strains, specifically strains SS2, SS7, SS16, and SS30, were selected for genome resequencing due to their possession of distinct mating loci. Strain SS16 shares the A1 mating locus with strain SS30, while strain SS2 shares the A2 locus with strain SS7. Additionally, strain SS16 shares the B1 locus with strain SS7, and strain SS2 shares the B2 locus with strain SS30 (Figure 7). In total, the sequencing yielded 4.0 Gb (approximately 56×), 3.2 Gb (approximately 44×), 4.0 Gb (approximately 56×), and 4.9 Gb (approximately 63×) data for strains SS2, SS7, SS16, and SS30, respectively. The genomes were subsequently assembled to sizes of 72.0 Mb, 72.5 Mb, 71.8 Mb, and 77.2 Mb for strains SS2, SS7, SS16, and SS30, respectively. The corresponding genes for HD and PR were annotated using Softberry (http://www.softberry.com/, accessed on 5 September 2024) and BLAST.

Figure 7.
The distribution of mating loci in parent strain and monokaryotic offspring. A1, A2 indicate different mating type A loci, B1, B2 indicate different mating type B loci.
A comparative analysis of the mating loci A1 and A2 reveals significant sequence divergence between these loci. The nucleotide identity between A1 and A2 is only 34.82% and 45.79% for HD1 and HD2, respectively, while the protein identity is markedly lower, at 8.95% and 17.32% for HD1 and HD2 (Supplementary Figure S5). That presents the HD1 and HD2 codetermined the mating A types. In contrast to the mating loci A, only half of the PR genes exhibit substantial sequence divergence. Specifically, PR1, PR2, and PR3 demonstrate minimal variation, with nucleotide identities of 99.94%, 99.78%, and 99.93%, respectively, and a protein identity of 100% for all three genes. Conversely, PR4, PR5, and PR6 show considerable differences between B1 and B2, with nucleotide identities of 35.01%, 39.29%, and 41.43%, and protein identities of 27.54%, 27.72%, and 29.33%, respectively (Supplementary Figure S6). That presents the PR4, PR5 and PR6 codetermined the mating B types. Which in accordance with the results, the primers designed on HD1 and PR4, PR5 can distinguish monokaryotic strains with different mating-types.
3.7. The Number of Sterigma and Basidiospores Observed by SEM
The quantity of basidiospores and sterigma per basidium significantly influences the life cycle of fungi. To facilitate a comprehensive examination of the hymenium structure, the magnification was gradually increased (Figure 8). Based on the results obtained from SEM observations of the hymenium, only four-sterigma basidia were identified (Figure 8A), with each basidium producing four basidiospores (Figure 8B). This finding is consistent with the characteristics observed in the majority of common mushroom species.

Figure 8.
Hymenium morphology observed by SEM. (A) Image of hymenium magnified 800 times. (B) Four-sterigma basidium with four basidiospores. (C) Basidiospores. Bar = 5 μm.
3.8. Nuclear Behaviors of Basidia and Basidiospores
The fragments of fruiting bodies were stained with DAPI, and the nuclear behavior was examined (Figure 9). Similar to other basidiomycetes, the initial two-nuclei stage was observed (Figure 9A), followed by the karyogamy process, during which fused nuclei were formed (Figure 9B). Meiosis subsequently occurred after karyogamy, resulting in the formation of two nuclei after meiosis I (Figure 9C), and four nuclei after meiosis II (Figure 9D). Furthermore, the process did not cease at this point; basidia containing eight nuclei were observed (Figure 9E), indicating that post-meiotic mitosis had taken place.

Figure 9.
Nuclear behaviors of basidia at different developmental stages. (A) Binucleate phase of young basidium, (B) karyogamy, (C) meiosis I, (D) meiosis II, (E) post-meiotic mitosis. Arrows indicate the nuclei. Bar = 5 μm.
The number of nuclei in basidiospores significantly influences the complexity of the life cycle. In P. umbellatus, only uninucleate basidiospores were observed (Figure 10), indicating that each basidiospore possesses a single mating-type. Consequently, P. umbellatus exhibits a relatively simple heterothallic life cycle.

Figure 10.
Nuclear staining of basidiospores with DAPI. Bar = 5 μm.
4. Discussion
The cultivation of P. umbellatus is predominantly reliant on sclerotia through asexual reproduction, which has led to significant homogenization and degeneration of seed sclerotia. In contrast, sexual reproduction has proven to be an effective strategy for addressing these challenges, with a clear mating system serving as the foundation for implementing sexual breeding. This study comprehensively elucidates the tetrapolar mating system of P. umbellatus by integrating mating-type loci analysis derived from genomic data with empirical mating tests. Furthermore, the heterothallic life cycle of this species is also characterized. These findings are expected to advance both the genetic research and breeding practices associated with P. umbellatus.
4.1. Study Methods of Mating System
The mating system serves as a fundamental basis for conducting genetic studies and breeding programs. Consequently, the investigation of mating systems has gained prominence in the context of edible and medicinal mushrooms. Notably, certain species exhibit unique sexual life cycles, which enhance the appeal of such studies; examples include Agaricus bisporus [27], Volvariella volvaceae [28], and W. hoelen [29]. The traditional approach to studying mating systems has involved a three-round mating test, which has been employed for the majority of species [30,31,32,33,34]. However, advancements in genomics and molecular technologies have led to the emergence of more effective methodologies, including the differentiation of monokaryotic and homokaryotic strains [35,36]. In previous research, a method for distinguishing homokaryotic strains of W. hoelen based on single nucleotide polymorphisms (SNPs) in the rpb2 gene was developed, representing a critical component of the mating system study for this species [29].
The mating-type loci have been identified as key regulators of mating in mono- or homokaryotic strains possessing compatible mating-type loci. Consequently, these loci would become the primary focus of research, while mating tests have served as supplementary methods. However, some studies have opted to forgo mating tests altogether. In the present study, both mating tests and mating-type loci analyses were conducted, which confirmed the existence of a tetrapolar mating system in P. umbellatus. With the reduction in sequencing costs, the genomes of various species have been published [37,38,39,40], and the analysis of mating-type loci has become a standard component of genomic studies [41,42]. This development presents a unique opportunity to investigate mating systems, and it is anticipated that numerous species will have their mating systems elucidated as their genomes are sequenced.
4.2. Nuclear Distribution and Migration Model in Basidia and Basidiospores
Nuclear distribution and migration present a complex and intriguing area of study, characterized by significant observational challenges [43,44]. Previous research has identified and categorized the nuclear distribution models across various species into six distinct types. Type I illustrates the formation of eight nuclei within the basidia through the processes of meiosis and subsequent post-meiotic mitosis, leading to the development of eight unicellular basidiospores. Type II describes a scenario in which post-meiotic mitosis occurs within the sterigma, resulting in the allocation of four nuclei to four basidiospores, thereby producing four unicellular basidiospores, while the remaining four nuclei revert to the basidia. Type III indicates that post-meiotic mitosis takes place within four basidiospores, with one nucleus returning to the basidia for each basidiospore, ultimately yielding four unicellular basidiospores. Type IV depicts a situation where post-meiotic mitosis occurs within four basidiospores, culminating in the formation of four binucleate basidiospores. Type V outlines the formation of four nuclei post-meiosis, which are then allocated to four basidiospores, resulting in four unicellular basidiospores. Finally, Type VI describes the formation of eight nuclei following post-meiotic mitosis within the basidia, which are subsequently transferred to form four binucleate basidiospores [45]. In addition to these six models, other variations exist. For instance, in A. bisporus, only two basidiospores are formed from a single basidium, with four nuclei being allocated to these two basidiospores, resulting in the formation of two binucleate basidiospores [46]. The current study observes the formation of eight nuclei within the basidia, with only four nuclei being transferred to produce four unicellular basidiospores, suggesting the emergence of a novel model. Thus, there are at least eight distinct models of nuclear distribution and migration in the basidia and basidiospores of basidiomycetes.
4.3. Heterothallic Life Cycle of Polyporus umbellatus
According to the findings of this study, the sexual life cycle of P. umbellatus has been summarized (Figure 11). The fruiting body represents the sexual stage (Figure 11K), while the hymenium functions as the sexual “organ”, basidia are formed, where karyogamy occurs (Figure 11A,B), followed by meiosis (Figure 11B,C) and post-meiotic mitosis (Figure 11C,D). Subsequently, the nuclei are transferred from the basidia to the basidiospores, resulting in the formation of four basidiospores per basidium (Figure 11E), with each basidium containing a single nucleus (Figure 11F). Four distinct basidiospore types are produced (Figure 11F1–F4), each exhibiting different mating-types: A1B1, A2B2, A1B2, and A2B1. Following this, the basidiospores germinate into monokaryotic hyphae (Figure 11G). Hyphae that carry compatible mating-type loci are capable of mating (Figure 11H), leading to the formation of dikaryotic hyphae (Figure 11I). Typically, the dikaryotic mycelia can directly develop into sclerotia (Figure 11J) and fruiting bodies (Figure 11K2), with fruiting bodies also capable of arising from sclerotia (Figure 11K1).

Figure 11.
Heterothallic life cycle of Polyporus umbellatus. (A) Binucleate phase of young basidium, (B) karyogamy, (C) meiosis, (D) post-meiotic mitosis, (E) formation of basidiospores, (F) basidiospores (F1. ininucleate spore with mating-type A1B1. F2. uninucleate spore with mating-type A2B2. F3. uninucleate spore with mating-type A1B2. F4. uninucleate spore with mating-type A2B1), (G) monokaryotic hypha (G1. monokaryotic hypha with mating-type A1B1. G2. monokaryotic hypha with mating-type A2B2. G3. monokaryotic hypha with mating-type A1B2. G4. monokaryotic hypha with mating-type A2B1), (H) plasmogamy, (I) dikaryotic hypha, (J) sclerotia, (K) fruiting bodies (K1. fruiting bodies formed on sclerotia. K2. fruiting bodies formed on artificial media). Question mark indicates that there is no evidence.
While there are some steps in the process remain ambiguous, such as the nuclear migration model from basidia to basidiospores, the formation of dikaryotic mycelia into sclerotia and fruiting bodies has not yet been achieved. Consequently, we have to collect fruiting bodies from the field. Previous research has extensively investigated the induction of sclerotia and fruiting bodies using pure spawn. Notably, Pasailiuk (2020) was the first to report on the artificial cultivation of fruiting bodies of P. umbellatus, marking a unique contribution to the field [12]. In China, numerous attempts have been made to cultivate sclerotia [47,48,49,50]; however, only minimal sclerotia-shaped tissue has been produced, and there has yet to be a successful application of pure spawn for the cultivation of sclerotia of P. umbellatus. Given that sclerotia and fruiting bodies represent the medicinal and edible components of this species, further research in this area is warranted.
4.4. Mating-Type Loci Structure
The species exhibiting a tetrapolar mating system, governed by unlinked mating-type A and B loci, includes P. umbellatus. This species has been shown to possess a tetrapolar mating system, with the mating-type A loci located on Contig 2 and the mating-type B loci situated on Contig 10. To date, the genome of P. umbellatus represents the first complete genome sequenced for the genus Polyporus, as P. brumalis, P. arcularius, and P. squamosus have been reclassified into other genera based on taxonomic revisions [51,52]. The structure of mating loci appears to be relatively conserved among basidiomycetes [53]. In comparison to other species within the order Polyporales, the mating-type loci of Grifola frondosa have recently been characterized [30]. This species contains one pair of HD genes and six PR genes, exhibiting structural similarities to P. umbellatus. Additionally, both W. hoelen and W. cocos possess three HD genes and four PR genes, while Laetiporus sulphureus has four HD genes and two PR genes [25]. All these species exhibit one pair of HD genes oriented in opposite directions, along with additional HD genes. Specifically, the third HD gene is located at a considerable distance from the HD1-HD2 pair downstream of the MIP in W. hoelen and W. cocos, whereas the additional HD genes in L. sulphureus are situated between the MIP and HD2 [25]. In Sparassis latifolia and S. crispa, one pair of HD genes and six PR genes have been annotated. The MIP and β-fg genes are conserved, consistently located adjacent to the HD1-HD2 pair, although their orientation varies [54]. In the species G. frondosa, S. latifolia, and W. hoelen, the MIP gene is positioned on the side of HD2, with the β-fg gene on the side of HD1. Conversely, in Laccaria bicolor and Pleurotus djamor, the orientation is reversed [30]. The number of HD and PR genes, as well as the structure of mating loci, has undergone extensive evolutionary changes. A comprehensive analysis will elucidate the evolutionary processes based on genomic information from an increasing number of species.
5. Conclusions
Our study presents the inaugural sequencing and assembly of the genome of P. umbellatus utilizing both Nanopore and Illumina sequencing platforms. Through the annotation of mating-type loci, the differentiation of monokaryotic offspring exhibiting various mating-types, and the execution of pairing tests, we elucidated the tetrapolar mating system of P. umbellatus. Additionally, by integrating the resequencing of monokaryotic strains with distinct mating-types, we identified that HD1 and HD2 correspond to mating-type A, while PR4, PR5, and PR6 correspond to mating-type B. Ultimately, the heterothallic life cycle was characterized through nuclear fluorescent staining and scanning electron microscopy. This study not only advances the breeding and genetic research of P. umbellatus, but also serves as a successful case study in the molecular investigation of mating systems.
Supplementary Materials
The following supporting information can be downloaded at: https://www.mdpi.com/article/10.3390/jof11010015/s1. Figure S1: Gene structure of HD genes of mating-type locus A; Figure S2: Gene structure of PR genes of mating-type locus B; Figure S3: Protein sequence alignment of six PR genes; Figure S4: Mon-to-Mon pairing tests; Figure S5: Alignment of HD genes of mating loci A1 and A2; Figure S6: Alignment of PR genes of mating loci B1 and B2; Table S1: Genome size of different species in Polyporales; Table S2: Statistics of illumina data mapping of P. umbellatus genome; Table S3: Statistics of BUSCO evaluation of P. umbellatus genome; Table S4: Annotation statistics of P. umbellatus coding genes; Table S5: Statistics of BUSCO evaluation of P. umbellatus gene prediction; Table S6: Statistics of non-coding RNA annotation results in P. umbellatus; Table S7: Length of HD and PR genes in P. umbellatus.
Author Contributions
Conceptualization, S.L. and S.G.; methodology, S.L.; software, S.L.; validation, Y.L. and L.L.; formal analysis, Y.L.; investigation, L.L.; resources, S.L.; data curation, B.L.; writing—original draft preparation, S.L.; writing—review and editing, S.G.; visualization, S.L.; supervision, S.G.; project administration, S.G.; funding acquisition, B.L. and S.G. All authors have read and agreed to the published version of the manuscript.
Funding
This research was funded by the Fundamental Research Funds for the Central Universities, Peking Union Medical College (Grant Number: 3332023052) and CAMS Innovation Fund for Medical Sciences (Grant Numbers: 2023-I2M-2-006, 2021-I2M-1-031, 2022-I2M-2-001).
Institutional Review Board Statement
Not applicable.
Informed Consent Statement
Not applicable.
Data Availability Statement
The data presented in this study are available in the Supplementary Figures and Tables. The genome of Polyporus umbellatus has been submitted to NCBI with BioProject: PRJNA1153740, accession numbers: JBGTYJ000000000, JBJZPE000000000, JBJZPF000000000, JBJZPG000000000, JBJZPH000000000, SRR31745029, SRR31745030, SRR31745027, SRR31745028.
Acknowledgments
We are grateful to Xiaoqiang Zhang and Hongyang Fang, who helped us a lot with material collection.
Conflicts of Interest
The authors declare no conflicts of interest.
References
- Xing, Y.M.; Zhang, L.C.; Liang, H.Q.; Lv, J.; Song, C.; Guo, S.X.; Wang, C.L.; Lee, T.S.; Lee, M.W. Sclerotial formation of Polyporus umbellatus by low temperature treatment under artificial conditions. PLoS ONE 2013, 8, e56190. [Google Scholar] [CrossRef] [PubMed]
- Xing, Y.M.; Yin, W.Q.; Liu, M.M.; Wang, C.L.; Guo, S.X. Oxalic acid and sclerotial differentiation of Polyporus umbellatus. Sci. Rep. 2015, 5, 10759. [Google Scholar] [CrossRef]
- National Pharmacopoeia Committee. Pharmacopoeia of the People’s Republic of China; China Medical Science Press: Beijing, China, 2020; pp. 331–332. [Google Scholar]
- Bandara, A.R.; Rapior, S.; Bhat, D.J.; Kakumyan, P.; Chamyuang, S.; Xu, J.C.; Hyde, K.D. Polyporus umbellatus, an edible-medicinal cultivated mushroom with multiple developed health-care products as food, medicine and cosmetics: A review. Cryptogam. Mycol. 2015, 36, 3–42. [Google Scholar] [CrossRef]
- Ryvarden, L.; Melo, I. Poroid fungi of Europe. Synopsis Fungorum Fungiflora 2014, 31, 262–264. [Google Scholar]
- Wang, Y.N.; Wu, X.Q.; Zhang, D.D.; Hu, H.H.; Liu, J.L.; Nosratola, D.V.; Guo, Y.; Zhao, Y.Y.; Miao, H. Polyporus umbellatus protects against renal fibrosis by regulating intrarenal fatty acyl metabolites. Front. Pharmacol. 2021, 12, 633566. [Google Scholar] [CrossRef] [PubMed]
- Tan, X.L.; Guo, L.; Wang, G.H. Polyporus umbellatus (Pers.) Fries inhibited tumor cell proliferation and promoted tumor cell apoptosis by down-regulating AKT in breast cancer. Biomed. Pharmacother. 2016, 83, 526–535. [Google Scholar] [CrossRef]
- Guo, Z.; Zang, Y.; Zhang, L. The efficacy of Polyporus umbellatus (Pers.) Fries polysaccharide in treating hepatitis B in China. Prog. Mol. Biol. Transl. Sci. 2019, 163, 329–360. [Google Scholar] [CrossRef]
- Song, C.; Liu, M.M.; Xing, Y.M.; Guo, S.X. ESTs analysis of putative genes engaged in Polyporus umbellatus sclerotial development. Int. J. Mol. Sci. 2014, 15, 15951–15962. [Google Scholar] [CrossRef]
- Li, S.Q. Endangered Polyporus umbellatus need immediate conservation. Mod. Chin. Med. 2008, 10, 43–45. [Google Scholar] [CrossRef]
- Didukh, Y.P. Chervona Knyha Ukrainy. Roslynnyi Svit (Red Data Book of Ukraine; Vegetable Kingdom); Globalkonsaltyng: Kyiv, Ukraine, 2009. [Google Scholar]
- Pasailiuk, M.V. Growing of Polyporus umbellatus. Curr. Res. Environ. Appl. Mycol. J. Fungal Biol. 2020, 10, 457–465. [Google Scholar] [CrossRef]
- Shanxi, G.Z. New results of artificial cultivation of Polyporus umbellatus. J. Chin. Med. Mater. 1978, 1, 19–23. [Google Scholar]
- Ren, L.L.; Zhao, Z.H.; Yang, Y.; Kong, M.M.; An, N.N.; Cao, L.J.; Jin, H.; Li, T.X. Correlation between medicinal components and inorganic elements in Polyporus umbellatus from different habitats. J. Liaoning Uni TCM 2020, 22, 49–53. [Google Scholar] [CrossRef]
- Rodenburg, S.Y.A.; Terhem, R.B.; Veloso, J.; Stassen, J.H.M.; van Kan, J.A.L.; Turgeon, B.G. Functional analysis of mating type genes and transcriptome analysis during fruiting body development of Botrytis cinerea. mBio 2018, 9, e01939-17. [Google Scholar] [CrossRef] [PubMed]
- Li, S.J.; Li, B.; Xu, X.L.; Liu, Y.Y.; Xing, Y.M.; Guo, S.X. Insight into the nuclear distribution patterns of conidia and the asexual life cycle of Polyporus umbellatus. Fungal Biol. 2024, 128, 2032–2041. [Google Scholar] [CrossRef] [PubMed]
- Krueger, D. Monographic Studies in the Genus Polyporus (Basidiomycotina). Ph.D. Thesis, The University of Tennessee, Knoxville, NJ, USA, 2002. Available online: http://trace.tennessee.edu/utk_graddiss/2135 (accessed on 1 October 2024).
- Casselton, L.A.; Challen, M.P. The mating type genes of the Basidiomycetes. In Growth, Differentiation and Sexuality; The Mycota; Springer: Berlin/Heidelberg, Germany, 2006; pp. 357–374. [Google Scholar]
- Kües, U.; James, T.Y.; Heitman, J. Evolution of Fungi and Fungal-like Organisms; Springer Science & Business Media: Berlin/Heidelberg, Germany, 2011; Available online: https://link.springer.com/book/10.1007/978-3-031-29199-9 (accessed on 1 October 2024).
- Ju, Y.; Kim, S.; Kim, M.; Ryu, J.S.; Ro, H.S. Structure analysis of A and B mating type loci in a representative commercial strain of Pleurotus eryngii. Sci. Hortic. 2020, 274, 109686. [Google Scholar] [CrossRef]
- Lee, Y.J.; Kim, E.; Eom, H.; Yang, S.H.; Choi, Y.J.; Ro, H.S. Discovery and functional study of a novel genomic locus homologous to Bα-mating-type sublocus of Lentinula edodes. Mycobiology 2021, 49, 582–588. [Google Scholar] [CrossRef] [PubMed]
- Walker, B.J.; Abeel, T.; Shea, T.; Priest, M.; Abouelliel, A.; Sakthikumar, S.; Cuomo, C.A.; Zeng, Q.D.; Wortman, J.; Young, S.K.; et al. Pilon: An integrated tool for comprehensive microbial variant detection and genome assembly improvement. PLoS ONE 2014, 11, e112963. [Google Scholar] [CrossRef] [PubMed]
- Chen, C.J.; Wu, Y.; Li, J.W.; Wang, X.; Zeng, Z.H.; Xu, J.; Liu, Y.L.; Feng, J.T.; Chen, H.; He, Y.H.; et al. TBtools-II: A “one for all, all for one” bioinformatics platform for biological big-data mining. Mol. Plant 2023, 16, 1733–1742. [Google Scholar] [CrossRef]
- Simão, F.A.; Waterhouse, R.M.; Ioannidis, P.; Kriventseva, E.V.; Zdobnov, E.M. BUSCO: Assessing genome assembly and annotation completeness with single-copy orthologs. Bioinformatics 2015, 31, 3210–3212. [Google Scholar] [CrossRef]
- Doyle, J.J.; Doyle, J.L. A rapid DNA isolation procedure for small quantities of fresh leaf tissue. Phytochem. Bull. 1987, 19, 11–15. [Google Scholar]
- Li, S.J.; Meng, G.L.; Dong, C.H. Homokaryotic high-quality genome assembly of medicinal fungi Wolfiporia hoelen reveals auto-regulation and high-temperature adaption of probable two-speed genome. Int. J. Mol. Sci. 2022, 23, 10484. [Google Scholar] [CrossRef]
- Kamzolkina, O.; Volkova, V.; Kozlova, M.; Pancheva, E.; Dyakov, Y.; Callac, P. Karyological evidence for meiosis in the three different types of life cycles existing in Agaricus bisporus. Mycologia 2006, 98, 763–770. [Google Scholar] [CrossRef] [PubMed]
- Chen, B.Z.; Fu, J.S.; Long, Y.; Zhang, L.; Zhang, X.Y.; Zhang, X.; Hu, F.L.; Jiang, Y.J.; Xie, B.G. Sexual life cycle of Volvariella volvacea revealed by investigation of the random migration of tetrad. Mycosystema 2017, 36, 466–472. [Google Scholar] [CrossRef]
- Li, S.J.; Wang, Q.; Dong, C.H. Bipolar system of sexual incompatibility and heterothallic life cycle in the basidiomycetes Pachyma hoelen Fr. (Fuling). Mycologia 2022, 114, 63–75. [Google Scholar] [CrossRef]
- Zhang, S.S.; Li, X.; Li, G.J.; Huang, Q.; Tian, J.H.; Wang, J.L.; Li, M.; Li, S.M. Genetic and molecular evidence of a tetrapolar mating system in the edible mushroom Grifola frondosa. J. Fungi 2023, 9, 959. [Google Scholar] [CrossRef]
- Wang, S.X.; Liu, Y.; Geng, X.L.; Wang, L.Q.; Meng, L.L. Study on mating system of Oudemansiella rsdicata. J. Anhui Agric. Sci. 2009, 37, 12547–12548. [Google Scholar] [CrossRef]
- Zhang, M.; Zhang, J.J.; Liu, J.J.; Liu, N.; Li, H. Study on morphology and cultivation of monokaryotic mycelia on Pholiota microspora. Acta Agriculturae Boreali-Sinica 2011, 26, 219–222. [Google Scholar]
- Wang, H.; Cao, H. Study on mating system of Stropharia rugosoannulata. Acta Edulis Fungi 2006, 13, 9–11. [Google Scholar] [CrossRef]
- Yao, F.J.; Zhang, Y.M.; Li, Y. Study on characteristics of mating-type system in Pleurotus nebrodensis. Mycosystema 2005, 24, 539–542. [Google Scholar] [CrossRef]
- James, T.Y.; Sun, S.; Li, W.; Heitman, J.; Kuo, H.C.; Lee, Y.H.; Asiegbu, F.O.; Olson, A. Polyporales genomes reveal the genetic architecture underlying tetrapolar and bipolar mating systems. Mycologia 2013, 105, 1374–1390. [Google Scholar] [CrossRef]
- Ohm, R.; de Jong, J.F.; Lugones, L.G.; Aerts, A.; Kothe, E.; Stajich, J.E.; de Vries, R.P.; Record, E.; Levasseur, A.; Baker, S.E.; et al. Genome sequence of the model mushroom Schizophyllum commune. Nat. Biotechnol. 2010, 28, 957–963. [Google Scholar] [CrossRef]
- Chen, S.L.; Xu, J.; Liu, C.; Zhu, Y.J.; Nelson, D.R.; Zhou, S.G.; Li, C.F.; Wang, L.Z.; Guo, X.; Sun, Y.Z.; et al. Genome sequence of the model medicinal mushroom Ganoderma lucidum. Nat. Commun. 2012, 1, 913. [Google Scholar] [CrossRef] [PubMed]
- Li, S.W.; Zhao, S.X.; Hu, C.H.; Mao, C.Z.; Guo, L.Z.; Yu, H.L.; Yu, H. Whole genome sequence of an edible mushroom Stropharia rugosoannulata (Daqiugaigu). J. Fungi 2022, 2, 99. [Google Scholar] [CrossRef] [PubMed]
- Sun, T.; Zhang, Y.X.; Jiang, H.; Yang, K.; Wang, S.Y.; Wang, R.; Li, S.; Lei, P.; Xu, H.; Qiu, Y.B.; et al. Whole genome sequencing and annotation of Naematelia aurantialba (Basidiomycota, edible-medicinal fungi). J. Fungi 2021, 1, 6. [Google Scholar] [CrossRef] [PubMed]
- Zhu, L.P.; Gao, X.; Zhang, M.H.; Hu, C.H.; Yang, W.J.; Guo, L.Z.; Yang, S.; Yu, H.L.; Yu, H. Whole genome sequence of an edible mushroom Oudemansiella raphanipes (Changgengu). J. Fungi 2023, 2, 266. [Google Scholar] [CrossRef] [PubMed]
- Duan, Y.C.; Han, H.Y.; Qi, J.Z.; Gao, J.M.; Xu, Z.C.; Wang, P.C.; Zhang, J.; Liu, C.W. Genome sequencing of Inonotus obliquus reveals insights into candidate genes involved in secondary metabolite biosynthesis. BMC Genom. 2022, 23, 314. [Google Scholar] [CrossRef] [PubMed]
- Gong, W.B.; Wang, Y.H.; Xie, C.L.; Zhou, Y.J.; Zhu, Z.H.; Peng, Y.D. Whole genome sequence of an edible and medicinal mushroom, Hericium erinaceus (Basidiomycota, Fungi). Genomics 2020, 112, 2393–2399. [Google Scholar] [CrossRef] [PubMed]
- Li, S.J.; Dong, C.H. Mating and crossbreeding systems of Wolfiporia hoelen. J. Fungal Res. 2023, 21, 143–150. [Google Scholar] [CrossRef]
- Zhao, J.X.; Feng, W.L.; Jin, Q.L.; Shen, Y.Y.; Song, T.T.; Cai, W.M. Microscopic observation of the morphological development of basidia and basidiospores in Agaricus bisporus. Acta Hortic. Sin. 2019, 46, 356–364. [Google Scholar] [CrossRef]
- Campos, A.N.; Costa, M.D. Basidiosporogenesis, meiosis, and post-meiotic mitosis in the ectomycorrhizal fungus Pisolithus microcarpus. Fungal Genet. Biol. 2010, 47, 477–483. [Google Scholar] [CrossRef] [PubMed]
- Sonnenberg, A.S.M.; Baars, J.J.P.; Hendrickx, P.M.; Lavrijssen, B.; Gao, W.; Weijn, A.; Mes, J.J. Breeding and strain protection in the button mushroom Agaricus bisporus. In Proceedings of the 7th International Conference on Mushroom Biology and Mushroom Products (ICMBMP7), Arcachon, France, 4–7 October 2011. [Google Scholar]
- Guo, S.X.; Wang, Q.Y.; Zhang, J.H.; Xia, H.Y. Studies on the cultivation method of sclerotium forming from hyphae of Grifola umbellata. Chin. Pharm. J. 2001, 36, 658–660. [Google Scholar]
- Liu, Y.Y. Studies on Sclerotial Formation by Pure Culture and Mechanisms of Sclerotial Transformation of Polyporus umbellatus. Ph.D. Thesis, Chinese Academy of Medical Sciences, Beijing, China, 2008. [Google Scholar]
- Xie, S.Y. Different Culture Conditions on Mycelial Growth and Sclerotia Formation of Polyporus substitute cultivation. Master’s Thesis, Northwest A&F University, Yangling, China, 2016. [Google Scholar]
- Ma, Z.L. Study on Cultivation and Artificial Sclerotial Differentiation of Polyporus umbellatus. Master’s Thesis, Northwest A&F University, Yangling, China, 2020. [Google Scholar] [CrossRef]
- Zmitrovich, I.V. The taxonomical and nomenclatural characteristics of medicinal mushrooms in some genera of Polyporaceae. Int. J. Med. Mushrooms 2010, 12, 87–89. [Google Scholar] [CrossRef]
- Binder, M.; Justo, A.; Riley, R.; Salamov, A.; Lopez-Giraldez, F.; Sjökvist, E.; Copeland, A.; Foster, B.; Sun, H.; Larsson, E.; et al. Phylogenetic and phylogenomic overview of the Polyporales. Mycologia 2013, 105, 1350–1373. [Google Scholar] [CrossRef] [PubMed]
- Kües, U. From two to many: Multiple mating types in basidiomycetes. Fungal Biol. Rev. 2015, 29, e166. [Google Scholar] [CrossRef]
- Li, Y.Q.; Yang, Y.; Huang, X.H.; Huang, J.; Dong, C.H. Molecular and genetic evidence for a tetrapolar mating system in Sparassis latifolia. Fungal Biol. 2020, 124, 1004–1012. [Google Scholar] [CrossRef] [PubMed]
Disclaimer/Publisher’s Note: The statements, opinions and data contained in all publications are solely those of the individual author(s) and contributor(s) and not of MDPI and/or the editor(s). MDPI and/or the editor(s) disclaim responsibility for any injury to people or property resulting from any ideas, methods, instructions or products referred to in the content. |
© 2024 by the authors. Licensee MDPI, Basel, Switzerland. This article is an open access article distributed under the terms and conditions of the Creative Commons Attribution (CC BY) license (https://creativecommons.org/licenses/by/4.0/).